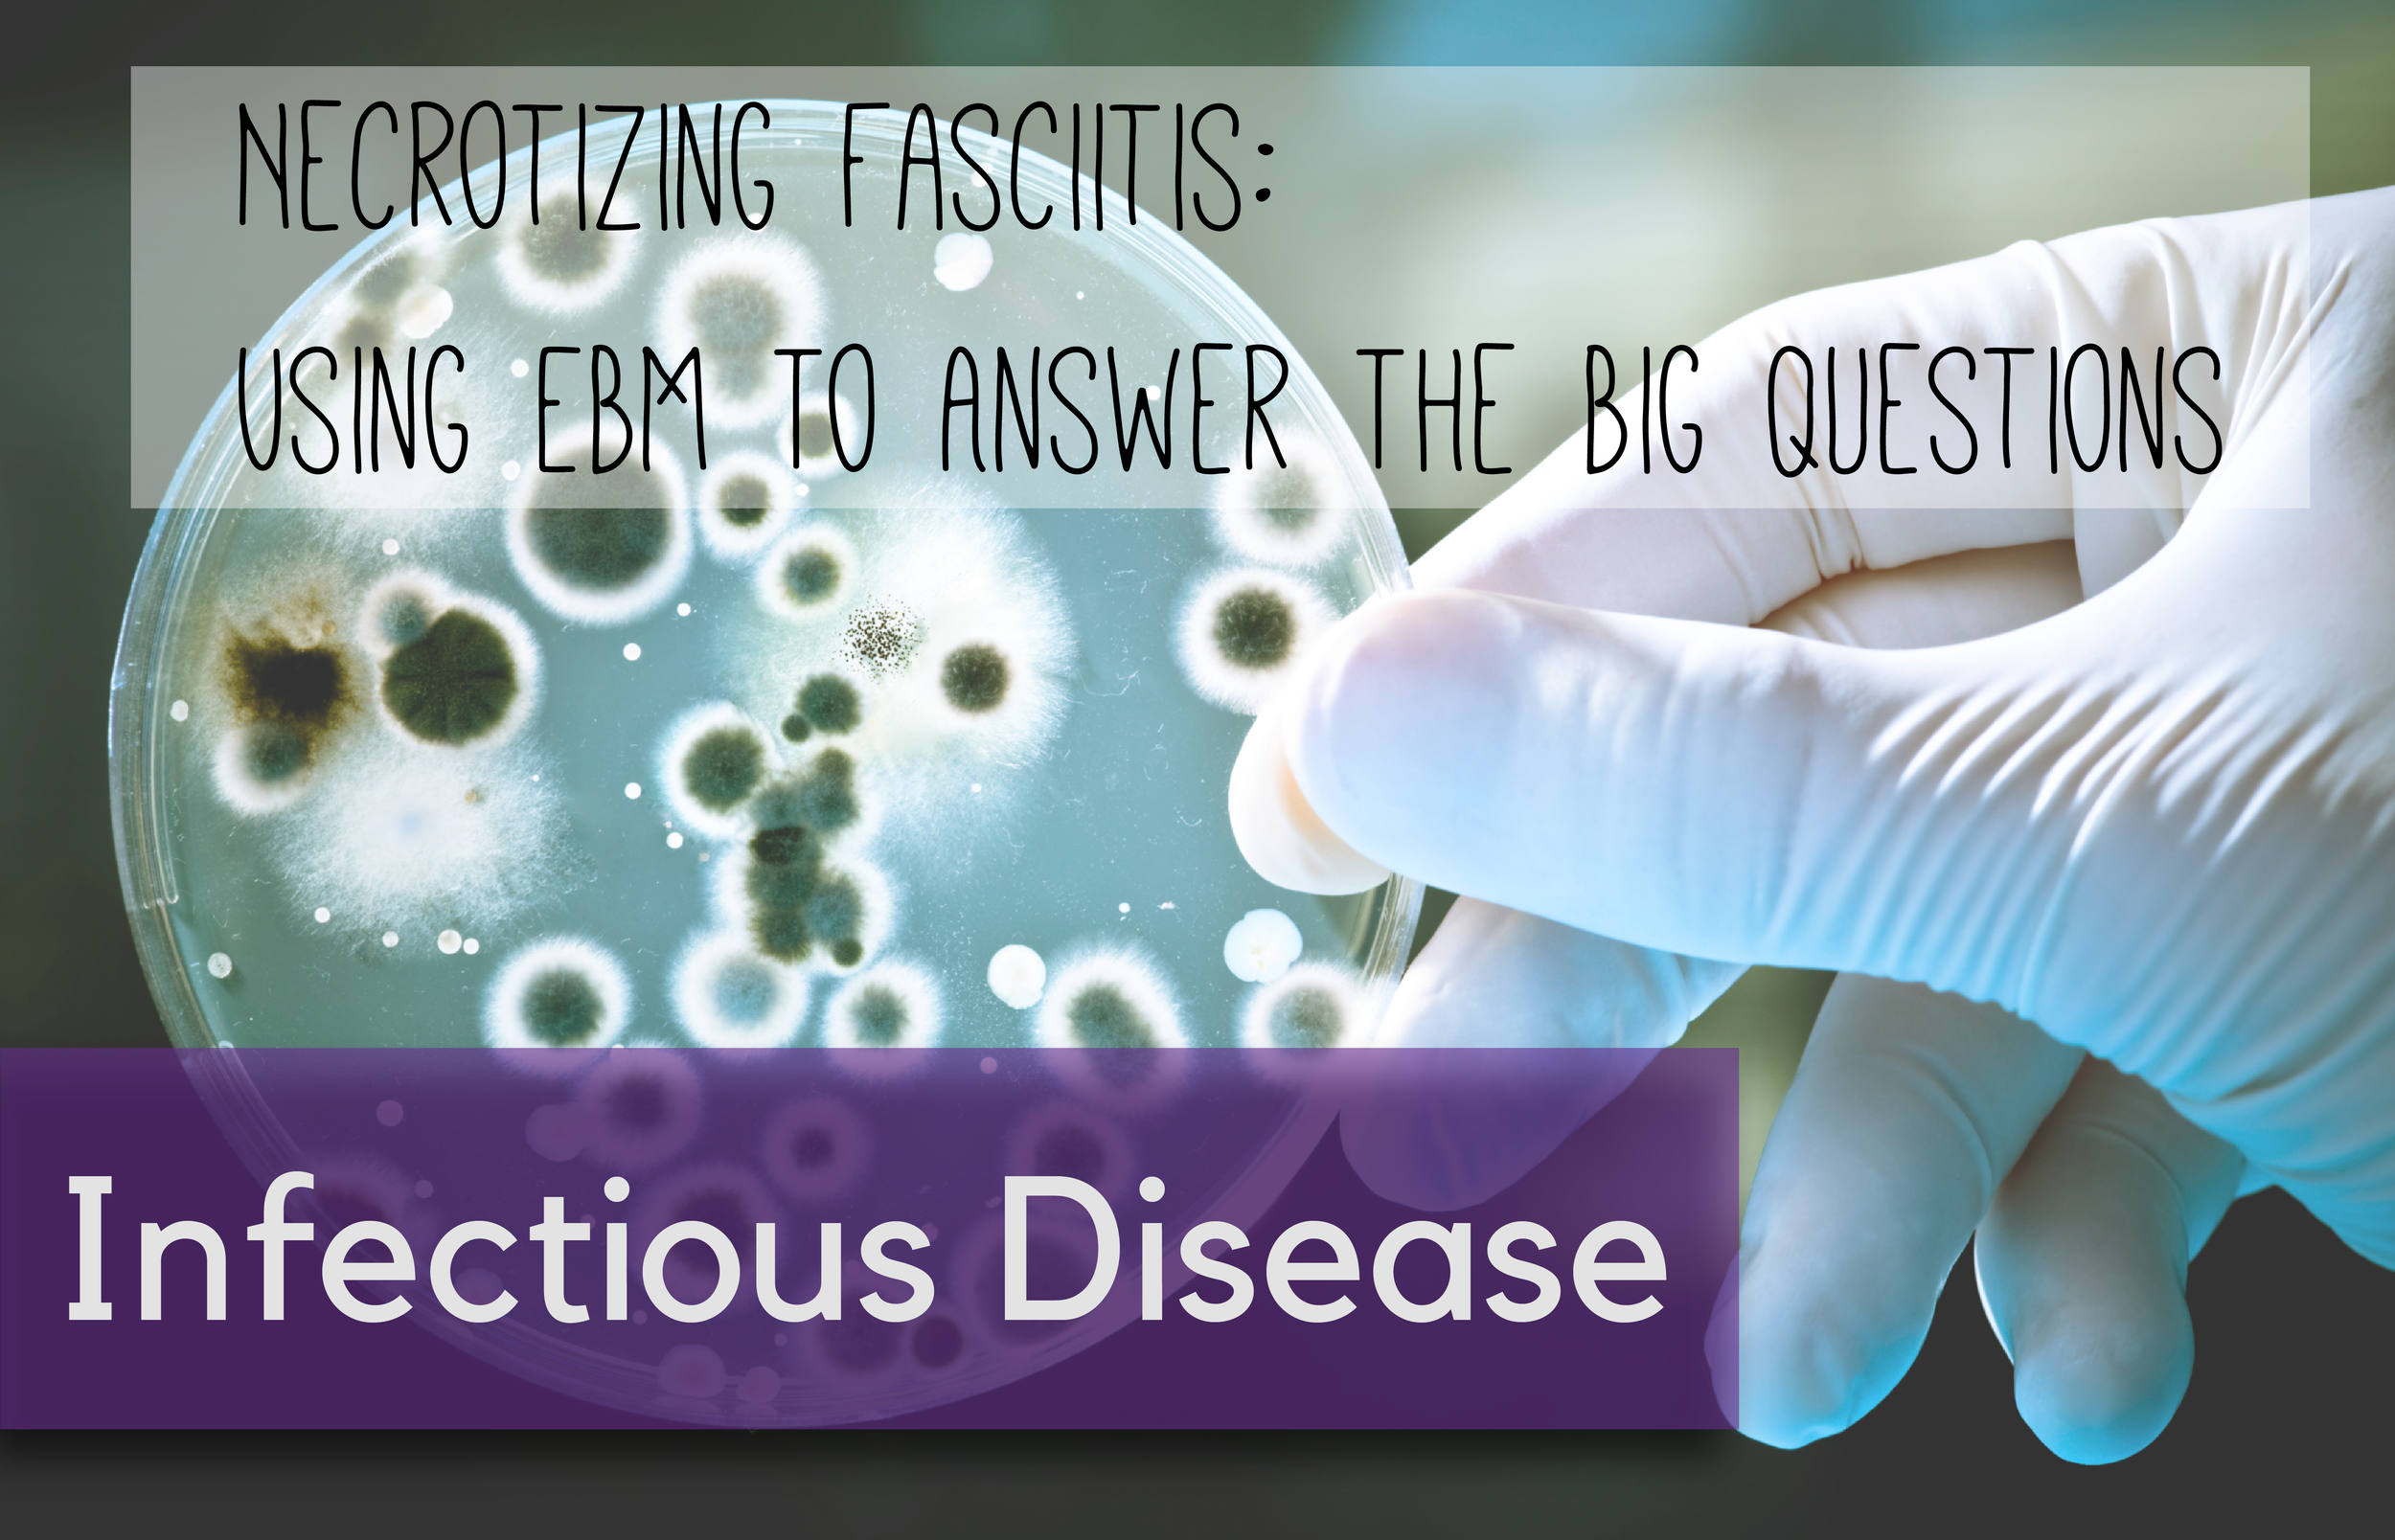

Written by: Danielle Miller, MD (EM Resident Physician, PGY-2, NUEM); Edited by: Carrie Pinchbeck, MD (EM Resident Physician, PGY-4, NUEM); Expert Commentary by: Kari Krueger, MD, Shannon Galvin, MD
Introduction
During my first months in the Emergency Department, I had a patient who screened positive for HIV. To be honest, I was unprepared for the conversation. After delivering the initial news that he had, in fact, screened positive for HIV and would need a confirmatory test, in turmoil, he rapidly stated:
“I can’t believe this. Is there treatment? How will I pay for treatment if I don’t have insurance? I will never be able to have sex again. No one will every marry me. Am I going to die?”
I told him the basics about HIV, and the classic line to “not worry” and that “we would link him to people who could help him.” And while this may have been a small comfort to him, this indeed was a failure to him. In emergency medicine, we pride ourselves on being excellent diagnosticians, but that skill is useless if we cannot benefit our patients by also being experts in the delivery of said diagnoses. At the time, I wish I had had a list of facts and commonly asked questions, to provide concise and confident answers to my patient. I hope that the content below can be that resource, especially considering that the incidence of newly positive HIV screening in the ED continues to increase.
Why this topic is important?
Testing for HIV in the emergency department (ED) has become a vital topic and policy in hospitals across the country. Early diagnosis of HIV is critical in decreasing transmission rates, in addition to providing better outcomes for patients, as early diagnosis often leads to earlier treatment. Multiple studies have shown that a large proportion of HIV positive individuals present to the ED 1-3 years prior to their initial diagnosis [1,2,3]. Thus, offering HIV testing in the ED is an important aspect of public health. The official policy of the American College of Emergency Physicians as of 2014 is to provide HIV testing in a timely and efficient manner, while the Center for Disease Control recommends HIV screening for patients aged 13–64 in all health-care settings and all pregnant women [4,5]. However, despite this push for more testing, there are few resources that aid emergency physicians in counseling their patients on new diagnoses of HIV.
Counseling A Patient with a New HIV Diagnosis
Below is a list of questions often asked by newly diagnosed patients. Also included are simple, concise answers that emergency physicians can use as an aid in counseling their patients on their new diagnosis.
What is HIV?
HIV or Human Immunodeficiency Virus is a virus that attacks your body’s immune system and prevents you from fighting infections [6].
Are you sure that I am positive?
You have a positive result on your preliminary test. You will need a second confirmatory test. Only if both tests are positive can you be diagnosed with HIV. It takes one week for the results of the second test to return. It is extremely important to follow-up with the results of the second test, so that you are aware of your diagnosis and can seek treatment early [6].
Do I have AIDS?
Not necessarily. AIDS is the last stage of HIV [7].
How is HIV treated?
Your body cannot get rid of HIV on its own. You need medications [6].
When will I die?
HIV is not a death sentence as long as you take medications. In fact there are more than 1 million people in the U.S. living with HIV [6]. Life expectancy for individuals diagnosed with HIV who start treatment early and take their medications consistently is similar to that of HIV negative individuals [4].
How does HIV spread?
HIV is spread through unprotected sex, sharing needles or syringes, from mother to unborn child, and through breastfeeding. It is important to use condoms to prevent against spread of HIV [7].
Do I need to tell anyone?
In Illinois you must tell potential sexual partners you have HIV or use a condom 100% of the time. We encourage you to tell any sexual partners or individuals that you have shared needles with recently [7].
Can I date someone and marry?
Yes, it is important to let your significant other know your HIV status. Using condoms prevents the risk of spreading the infection. Additionally, by taking medications, you can reduce the levels of virus in your body to prevent spreading to your partner. Your partner can also take medications to prevent spread from you to him/her—this is called pre-exposure prophylaxis [6].
I am pregnant and screened positive for HIV. Can the infection transmit to my baby?
Yes, the infection can pass to your baby during pregnancy, during vaginal delivery, and during breastfeeding. You can take medications during pregnancy to reduce the risk of your child getting HIV. Your baby will also be treated with medications for approximately 6 weeks after he or she is born. You should not breastfeed your baby [7].
If I have HIV, can I still get pregnant?
Yes. You can take medications to prevent transmitting the infection to your unborn child [7].
My screening test was negative, so I don’t have the disease?
There is a window period when the test cannot detect the infection, though you still may be infected. If the last time you engaged in high-risk sexual activity was over 3 months ago, then you likely do not have the disease. Sometimes it takes time for the virus to be detectable by our tests [6].
In Illinois, how can I afford my HIV prescriptions?
The Aids Foundation of Chicago is an excellent resource.
Medication assistance can be obtained through the Medication Assistance Program (MAP, formerly the AIDS Drug Assistance Program ADAP). This program can aid in up to $2,000 per month for medications, which is sufficient to cover all combinations of triple and quadruple therapies. Contact the AIDS Foundation of Chicago (AFC) at 312-922-2322 and say that you need a case manager [8,9]
In Illinois, if I test positive, does my doctor have to give my name to the Department of Health?
Yes. Illinois law requires that doctors report the names of their patients who test HIV-positive to the Department of Health [10].
In Illinois, if I test HIV positive, does my doctor have to tell my spouse, civil union partner, or sexual partner?
No. The only sexual partner your doctor is allowed to tell is your legal husband, wife, or civil union partner. If you don’t personally tell your spouse or civil union partner, then your doctor can tell them. But even then, the doctor is not required to tell them [10].
Take Home Points
- Testing for HIV in the ED is recommended by both the American College of Emergency Physicians and the Center for Disease Control
- It is important to counsel patients on their new diagnosis, including information on the disease itself and how the disease affects a patient’s social and financial health
- The overall message of counseling should be that HIV is virus that attacks a patient’s immune system and early treatment with medications is important and effective
- The patient should be advised on disease prevention and encouraged to tell their sexual partners
- Most importantly, patients should be linked to care, and given information on each hospital’s local and regional resources
- At Northwestern any provider can page the HIV rapid diagnosis pager 24 hours a day as soon as you have a preliminary positive result and an infectious disease physician can assist you in disclosing to the patient and arranging follow up.
Expert Commentary
This is an excellent topic for discussion and an important area for collaboration between the Emergency Department and Infectious Diseases to reduce barriers that make it challenging to perform HIV screening and link patients to care.
An estimated 10-15% of people living with HIV in the US are unaware of their status [11]. Early diagnosis is vital to prevent progression to advanced immunosuppression and reduce transmission of the virus [12]. It is now recommended that therapy be initiated for all patients with HIV regardless of CD4 count [13]. Frequently, patients who are diagnosed with advanced HIV have had multiple encounters with the health care system in the preceding years which represent missed opportunities for earlier diagnosis [1]. The emergency department evaluates a large number of high risk patients who often have limited access to primary care and thus serves as an important setting to perform screening. The CDC recommends testing for all individuals aged 13-64 at least once and more frequently for those with high risk behaviors. In the ED, at a minimum, you should screen all patients who are pregnant (without a documented HIV test during pregnancy) or who present with signs/symptoms of acute or chronic HIV including thrush, urogenital symptoms consistent with a sexually transmitted infection, suspected syphilis, and/or severe pneumonia.
Despite the proven health benefits of universal HIV screening, Northwestern Medicine has not yet fully implemented the 2006 CDC HIV testing guidelines. In order to improve HIV testing at Northwestern Hospital we initiated incremental interventions beginning in 2012 when the rapid 4th generation Abbott ARCHITECT® HIV Ag/Ab Combo (Abbott Laboratories, Germany) test replaced the 3rd generation HIV-1 antibody test. The Abbott ARCHITECT® HIV Ag/Ab Combo test is a fully automated platform with a turnaround time of 60 minutes for nonreactive results. This allowed more rapid turnaround times, and the ability to offer HIV testing in acute care settings. HIV testing was offered in the emergency department, outpatient and inpatient sites at the discretion of the physician.
To improve upon these laboratory advancements with a more systematic approach, approximately six months following availability of the 4th generation test, an enhanced testing and linkage to outpatient care program was initiated. This included the collaborative creation of the HIV Testing Policy and Procedure based on input by ID, ED and laboratory staff and a formal HIV Rapid Diagnosis Team. This policy identified patients who were pregnant and/or had thrush, severe pneumonia, or sexually transmitted infection symptoms as priority populations for testing, and detailed the procedure to obtain consent, order the test, and deliver the results. The ED or inpatient unit notified the ID physician of the HIV Rapid Diagnosis Team of the reactive HIV test 24 hours a day, and the ID physician or HIV APN immediately discussed the results with the patient while they were in the ED, either in person or by phone if after working business hours, and facilitated linkage to outpatient care. All patients were guaranteed a comprehensive initial visit in the Infectious Diseases Center within 1 week of their ED visit regardless of their insurance status.
During the baseline time period prior to these initiatives, 63 tests in 44,506 ED encounters were ordered in the first six months of 2012. After the 4th generation test was implemented, 49 tests in 43,640 encounters were ordered in the second six months. Once the testing policy and HIV Rapid Diagnosis Team were implemented, 192 tests in 45,094 encounters were ordered in the next six months of 2013. These results have been maintained with 553 tests ordered from the ED in 2014, 21 being positive for a 3.8% rate. Of the 21, 12 were new diagnoses, 8 were prior known positives and 1 false positive. Four of the 12 new diagnoses were acutely infected. This compares to a total of 2084 HIV tests ordered at Northwestern inpatient sites with 42 positive, giving a 2% positivity rate during 2014. Over 92% of all these HIV positive persons were linked to care and started antiretrovirals.
If the initial screen returns positive, then it is likely that the patient is infected with HIV but they will still require additional testing for confirmation as false positives do occur. If the patient is pregnant then your next step is to call the Illinois Perinatal HIV Hotline to engage the patient in care to reduce the risk of transmission to the fetus which can occur at any point during pregnancy. At Northwestern, if the patient is not pregnant, your next step should be to call the HIV Rapid Diagnosis Pager (available 24/7 through web paging) while the patient is still in the ED to discuss results with the on-call attending or fellow who can provide counseling (either in person or via phone overnight) and arrange follow-up.
If you are practicing at a facility without the immediate availability of an HIV specialist to assist in disclosure, then here are some recommended points to include in your discussion:
- The screening test is positive but we do not know for sure if you are infected with HIV until we get the confirmatory testing results back.
- Even if the HIV test comes back positive, there are safe and effective medications to keep you healthy and control the virus to prevent, and even repair, damage to your immune system.
- Regardless of your current insurance status or ability to pay, you will be able to receive care and medications to treat HIV.
- Until the results of the confirmatory testing are known, it is necessary to avoid spread of the virus by performing abstinence from all sexual activity (at a minimum must wear condoms during all sexual acts) and to refrain from sharing needles.
- It is extremely important to have short term follow-up with an HIV specialist to discuss the final results and, if needed, take the next steps toward treatment which includes medication to suppress the virus. There a lot of people and resources available to help patients with HIV and walk you through the next steps.
Disclosing a positive HIV result in a busy emergency department is not an easy task, but it is important to remember that providing the diagnosis sooner rather than later may ultimately allow that patient to live significantly longer with a better quality of life.
Kari Krueger, MD
Infectious Diseases Fellow; Northwestern University Feinberg School of Medicine
Shannon Galvin, MD
Associate Professor of Infectious Disease; Northwestern Medicine
Other Posts You May Enjoy
How to cite this blog post:
[Peer-Reviewed, Web Publication] Miller D, Pinchbeck C (2017, February 14). HIV Counseling in the ED: Commonly Asked Questions and How to Answer Them [NUEM Blog. Expert Commentary By Krueger K and Galvin S ]. Retrieved from http://www.nuemblog.com/blog/hiv-counseling
References
- Lyons MS, Lindsell CJ, Wayne DB, Ruffner AH, Hart KW, Fichtenbaum CJ, Trott AT, Sullivan PS. Comparison of missed opportunities for earlier HIV diagnosis in 3 geographically proximate emergency departments. Ann Emerg Med. 2011 Jul; 58(1 Suppl 1):S17-22.e1.
- Nakao JH, Wiener DE, Newman DH, Sharp VL, Egan DJ. Falling through the cracks? Missed opportunities for earlier HIV diagnosis in a New York City Hospital.Int J STD AIDS. 2014 Oct; 25(12):887-93.
- Lindsell CJ, Hart KW, Lyons MS. A simple method for estimating the prevalence of undiagnosed HIV infection in an emergency department. Ann Emerg Med. 2011 Jul; 58(1 Suppl 1):S23-7.
- “HIV Testing and Screening in the Emergency Department. “ Clinical Practice and Management, American College of Emergency Physicians, June 2014. http://www.acep.org/Clinical---Practice-Management/HIV-Testing-and-Screening-in-the-Emergency-Department/. 12 Jan 2016.
- “HIV Infection Detection, Counseling, and Referral.” STD Treatment Guidelines, The Center for Disease Control and Prevention, 28 Jan. 2011. http://www.cdc.gov/std/tg2015/hiv.htm. 12 Jan. 2016.
- “What Do I Do? A Handbook to Understanding Health and HIV.” What Do I Do If, The Human Rights Campaign, 2016. http://www.hrc.org/whatdoido. 12 Jan. 2016.
- “Newly diagnosed: What You Need to Know.” AIDS.gov, 10 April 2015. https://www.aids.gov/hiv-aids-basics/just-diagnosed-with-hiv-aids/overview/newly-diagnosed/. 12 Jan. 2016.
- “About HIV.” AIDS Foundation of Chicago, 2015. http://www.aidschicago.org/page/i-need/hiv-medications. 12 Jan. 2016.
- “ADAP: AIDS Drug Assistance Program.” Illinois Department of Health. http://www.idph.state.il.us/health/aids/adap.htm. 12 Jan. 2016.
- “HIV and Confidentiality.” AIDS Legal Council of Chicago, March 2014. http://aidslegal.com/wp-content/uploads/2014/05/HIV-and-Confidentiality.pdf. 12 Jan 2016.
- Hall HI, AN Q, Tang T, et al. Prevalence of Diagnosed and Undiagnosed HIV Infection—United States, 2008-2012. MMWR Morb Mortal Wkly Rep 2015; 64:657.
- Paltiel AD, Walenksy RP, Schackman BR, et al. Expanded HIV screening in the United States: effect on clinical outcomes, HIV transmission, and costs. Ann Intern Med 2006; 145:797.
- INSIGHT START Study Group, Lundgren JD, Babiker AG, et al. Initiation of Antiretroviral Therapy in Early Asymptomatic HIV Infection. N Enlg J Med 2015; 373:795.
- Branson BM, Handsfield HH, Lampe MA, et al. Revised recommendations for HIV testing of adults, adolescents, and pregnant women in health-care settings. MMRW Recomm Rep 2006; 55:1.